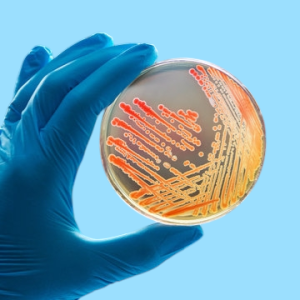
Microbiology

Application
-

Antibiotics110 Products
-

Antibodies6,860 Products
-

Assay Kit544 Products
-

Base/Nucleic Acid40 Products
-

Biochemicals1,013 Products
-

Buffers & Stock Solutions152 Products
-

Cell Biology263 Products
-

Dye/Indicator/Stain280 Products
-

Elisa kit14,414 Products
-

Harmone51 Products
-
Microbiology853 Products
-

Molecular Biology179 Products
-

Proteomics1,707 Products
-

Refference Standards1,511 Products
-

Vitamin20 Products
